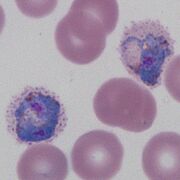
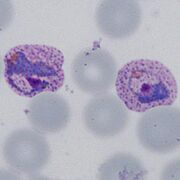
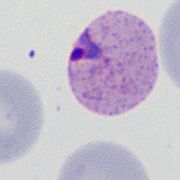
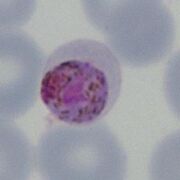
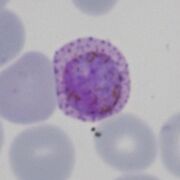
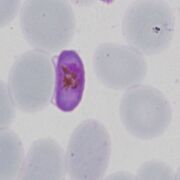
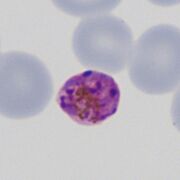
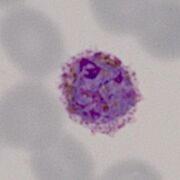
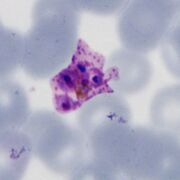

File list
This special page shows all uploaded files.
| Date | Name | Thumbnail | Size | User | Description | Versions |
|---|---|---|---|---|---|---|
| 18:22, 6 December 2024 | PFSc.jpg (file) |  |
45 KB | Admin | 1 | |
| 18:21, 6 December 2024 | PFLTc.jpg (file) |  |
41 KB | Admin | 1 | |
| 11:39, 6 December 2024 | Schuffner1.jpg (file) |  |
43 KB | Admin | 1 | |
| 11:39, 6 December 2024 | Mmaurer2.jpg (file) |  |
58 KB | Admin | 1 | |
| 11:39, 6 December 2024 | Mmaurer1.jpg (file) |  |
35 KB | Admin | 1 | |
| 11:38, 6 December 2024 | James1.jpg (file) |  |
48 KB | Admin | 1 | |
| 18:08, 5 December 2024 | PHincorrect2.jpg (file) |  |
97 KB | Admin | 1 | |
| 18:07, 5 December 2024 | PHincorrect.jpg (file) | |
76 KB | Admin | 1 | |
| 18:07, 5 December 2024 | PHcorrect.jpg (file) | |
68 KB | Admin | 1 | |
| 17:46, 5 December 2024 | Schizont release.jpg (file) |  |
60 KB | Admin | 1 | |
| 17:45, 5 December 2024 | PFET-synchronous.jpg (file) |  |
42 KB | Admin | 1 | |
| 09:54, 5 December 2024 | Ring special clinical.jpg (file) |  |
117 KB | Admin | 1 | |
| 09:51, 5 December 2024 | Ring special.jpg (file) |  |
50 KB | Admin | 1 | |
| 16:01, 3 December 2024 | 11multiple4.jpg (file) |  |
40 KB | Admin | 1 | |
| 16:01, 3 December 2024 | 11multiple3.jpg (file) |  |
40 KB | Admin | 1 | |
| 16:00, 3 December 2024 | 11multiple2.jpg (file) |  |
37 KB | Admin | 1 | |
| 16:00, 3 December 2024 | 11multiple1.jpg (file) |  |
30 KB | Admin | 1 | |
| 12:04, 3 December 2024 | 11accole main.jpg (file) |  |
40 KB | Admin | 1 | |
| 11:57, 3 December 2024 | 11accole3.jpg (file) | |
37 KB | Admin | 1 | |
| 11:57, 3 December 2024 | 11accole2.jpg (file) |  |
32 KB | Admin | 1 | |
| 11:57, 3 December 2024 | 11accole.jpg (file) |  |
27 KB | Admin | 1 | |
| 14:11, 2 December 2024 | Biology Gametocyte.jpg (file) |  |
66 KB | Admin | 1 | |
| 19:51, 30 November 2024 | PKG2.jpg (file) |  |
34 KB | Admin | 1 | |
| 19:49, 30 November 2024 | PMLG0.jpg (file) |  |
46 KB | Admin | 1 | |
| 19:49, 30 November 2024 | PMG3.jpg (file) |  |
120 KB | Admin | 1 | |
| 19:48, 30 November 2024 | PMG2.jpg (file) | |
30 KB | Admin | 1 | |
| 19:47, 30 November 2024 | POG5.jpg (file) | |
25 KB | Admin | 1 | |
| 19:47, 30 November 2024 | POG2.jpg (file) |  |
208 KB | Admin | 1 | |
| 19:46, 30 November 2024 | POG1.jpg (file) |  |
128 KB | Admin | 1 | |
| 19:40, 30 November 2024 | PVG3.jpg (file) |  |
46 KB | Admin | 1 | |
| 19:40, 30 November 2024 | PVG2.jpg (file) |  |
31 KB | Admin | 1 | |
| 19:37, 30 November 2024 | PFG3.jpg (file) | |
31 KB | Admin | 1 | |
| 19:37, 30 November 2024 | PFG2.jpg (file) |  |
41 KB | Admin | 1 | |
| 19:36, 30 November 2024 | PFG1.jpg (file) |  |
36 KB | Admin | 1 | |
| 17:36, 28 November 2024 | PMS4.jpg (file) |  |
79 KB | Admin | 1 | |
| 17:35, 28 November 2024 | PMS3.jpg (file) |  |
87 KB | Admin | 1 | |
| 17:35, 28 November 2024 | PMS2.jpg (file) |  |
74 KB | Admin | 1 | |
| 17:35, 28 November 2024 | PMS1.jpg (file) | |
78 KB | Admin | 1 | |
| 17:33, 28 November 2024 | PVS5.jpg (file) | |
28 KB | Admin | 1 | |
| 17:32, 28 November 2024 | PVS3.jpg (file) |  |
42 KB | Admin | 1 | |
| 17:32, 28 November 2024 | PVS2.jpg (file) |  |
41 KB | Admin | 1 | |
| 17:32, 28 November 2024 | PVS1.jpg (file) |  |
41 KB | Admin | 1 | |
| 17:30, 28 November 2024 | POS4.jpg (file) |  |
115 KB | Admin | 1 | |
| 17:30, 28 November 2024 | POS3.jpg (file) |  |
25 KB | Admin | 1 | |
| 17:29, 28 November 2024 | POS2.jpg (file) | |
44 KB | Admin | 1 | |
| 17:29, 28 November 2024 | POS1.jpg (file) |  |
48 KB | Admin | 1 | |
| 17:14, 28 November 2024 | PKS4.jpg (file) |  |
36 KB | Admin | 1 | |
| 17:14, 28 November 2024 | PKS3.jpg (file) |  |
22 KB | Admin | 1 | |
| 17:13, 28 November 2024 | PKS2.jpg (file) |  |
25 KB | Admin | 1 | |
| 17:13, 28 November 2024 | PKS1.jpg (file) |  |
27 KB | Admin | 1 |